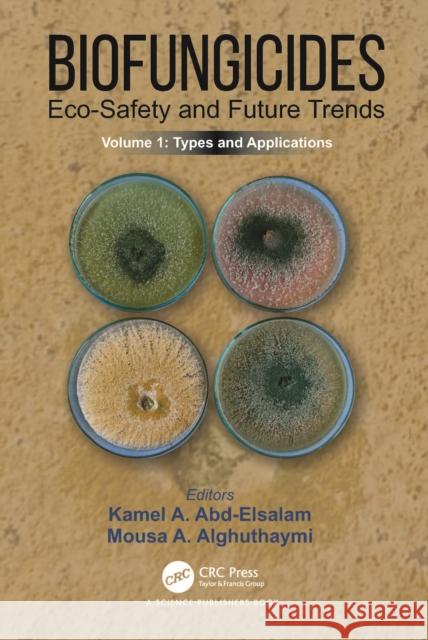

Książki: » Ekonomia i biznes » Biofungicides: Eco-Safety and Future Trends
topmenu
 | Biofungicides: Eco-Safety and Future Trends: Types and Applications, Volume 1
cena:326.10 zł |
| Biofungicides: Eco-Safety and Future Trends: Types and Applications, Volume 1
cena:326.10 zł |